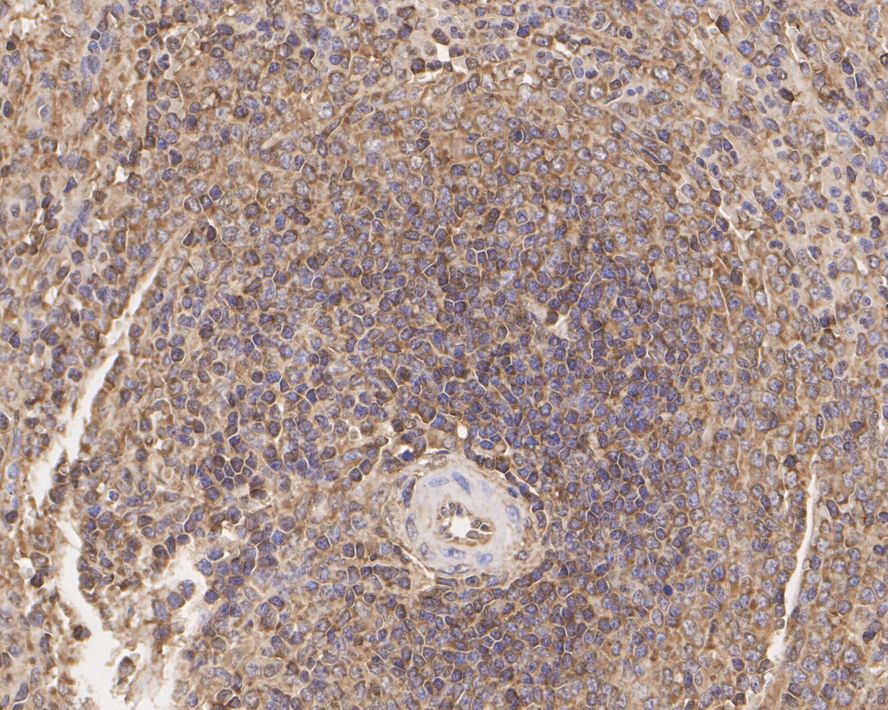

NF-kB p65 Recombinant Rabbit Monoclonal Antibody [SZ10-04] - BSA and Azide free

Rmb: 5600 特惠
产品规格
Catalog# HA750058
NF-kB p65 Recombinant Rabbit Monoclonal Antibody [SZ10-04] - BSA and Azide free
-
WB
-
IF-Cell
-
IF-Tissue
-
IHC-P
-
IP
-
FC
-
Human
-
Mouse
-
Rat
-
ET1603-12
含抗保成分
-
Zebrafish
-
unconjugated
Safety datasheet
概述
产品名称
NF-kB p65 Recombinant Rabbit Monoclonal Antibody [SZ10-04] - BSA and Azide free
抗体类型
Recombinant Rabbit monoclonal Antibody
免疫原
Synthetic peptide within human RELA aa 490-540.
种属反应性
Human, Mouse, Rat (Predicted: Zebrafish)
验证应用
WB, IF-Cell, IF-Tissue, IHC-P, IP, FC
分子量
Predicted band size: 65 kDa
阳性对照
A549 cell lysate, MCF7 cell lysate, HeLa cell lysate, RAW264.7 cell lysate, HeLa, human lung squamous cell carcinoma tissue, human lung cancer tissue, human lung tissue, human spleen tissue, mouse spleen tissue, rat spleen tissue.
偶联
unconjugated
克隆号
SZ10-04
产品特性
形态
Liquid
浓度
存放说明
Store at +4℃ after thawing. Aliquot store at -20℃ or -80℃. Avoid repeated freeze / thaw cycles.
存储缓冲液
1*PBS (pH7.4).
亚型
IgG
纯化方式
Protein A affinity purified.
应用稀释度
-
WB
-
1:5,000-1:10,000
-
IF-Cell
-
1:100-1:400
-
IF-Tissue
-
1:100-1:200
-
IHC-P
-
1:200-1:500
-
FC
-
1:2,000
-
IP
-
Use at an assay dependent concentration.
靶点
功能
Proteins encoded by the v-Rel viral oncogene and its cellular homolog, c-Rel, are members of a family of transcription factors that include the two subunits of the transcription factor NF kB (p50 and p65) and the Drosophila maternal morphogen, dorsal. Both proteins specifically bind to DNA sequences that are the same or slight variations of the 10 bp kB sequence in the immunoglobulin k light chain enhancer. This same sequence is also present in a number of other cellular and viral enhancers. The DNA binding activity of NFkB is activated and NFkB is subsequently transported from the cytoplasm to the nucleus in cells exposed to mitogens or growth factors. cDNAs encoding precursors for two distinct proteins of the same size have been described, designated p105 and p100. The p105 precursor contains p50 at its N-terminus and a C-terminal region that when expressed as a separate molecule, designated pdI, binds to p50 and regulates its activity.
背景文献
1. Kang K et al. Carnosic acid slows photoreceptor degeneration in the Pde6b(rd10) mouse model of retinitis pigmentosa. Sci Rep 6:22632 (2016).
2. Kropp KA et al. A temporal gate for viral enhancers to co-opt Toll-like-receptor transcriptional activation pathways upon acute infection. PLoS Pathog 11:e1004737 (2015).
翻译后修饰
Ubiquitinated by RNF182, leading to its proteasomal degradation. Degradation is required for termination of NF-kappa-B response.; Monomethylated at Lys-310 by SETD6. Monomethylation at Lys-310 is recognized by the ANK repeats of EHMT1 and promotes the formation of repressed chromatin at target genes, leading to down-regulation of NF-kappa-B transcription factor activity. Phosphorylation at Ser-311 disrupts the interaction with EHMT1 without preventing monomethylation at Lys-310 and relieves the repression of target genes (By similarity).; Phosphorylation at Ser-311 disrupts the interaction with EHMT1 and promotes transcription factor activity (By similarity). Phosphorylation on Ser-536 stimulates acetylation on Lys-310 and interaction with CBP; the phosphorylated and acetylated forms show enhanced transcriptional activity. Phosphorylation at Ser-276 by RPS6KA4 and RPS6KA5 promotes its transactivation and transcriptional activities.; Reversibly acetylated; the acetylation seems to be mediated by CBP, the deacetylation by HDAC3 and SIRT2. Acetylation at Lys-122 enhances DNA binding and impairs association with NFKBIA. Acetylation at Lys-310 is required for full transcriptional activity in the absence of effects on DNA binding and NFKBIA association. Acetylation at Lys-310 promotes interaction with BRD4. Acetylation can also lower DNA-binding and results in nuclear export. Interaction with BRMS1 promotes deacetylation of Lys-310. Lys-310 is deacetylated by SIRT2.; S-nitrosylation of Cys-38 inactivates the enzyme activity.; Sulfhydration at Cys-38 mediates the anti-apoptotic activity by promoting the interaction with RPS3 and activating the transcription factor activity.; Sumoylation by PIAS3 negatively regulates DNA-bound activated NF-kappa-B.; Proteolytically cleaved within a conserved N-terminus region required for base-specific contact with DNA in a CPEN1-mediated manner, and hence inhibits NF-kappa-B transcriptional activity.
亚细胞定位
Nucleus, Cytoplasm.
别名
Avian reticuloendotheliosis viral (v rel) oncogene homolog A antibody
MGC131774 antibody
NF kappa B p65delta3 antibody
NFKB3 antibody
Nuclear Factor NF Kappa B p65 Subunit antibody
Nuclear factor NF-kappa-B p65 subunit antibody
Nuclear factor of kappa light polypeptide gene enhancer in B cells 3 antibody
Nuclear factor of kappa light polypeptide gene enhancer in B-cells 3 antibody
OTTHUMP00000233473 antibody
OTTHUMP00000233474 antibody
展开Avian reticuloendotheliosis viral (v rel) oncogene homolog A antibody
MGC131774 antibody
NF kappa B p65delta3 antibody
NFKB3 antibody
Nuclear Factor NF Kappa B p65 Subunit antibody
Nuclear factor NF-kappa-B p65 subunit antibody
Nuclear factor of kappa light polypeptide gene enhancer in B cells 3 antibody
Nuclear factor of kappa light polypeptide gene enhancer in B-cells 3 antibody
OTTHUMP00000233473 antibody
OTTHUMP00000233474 antibody
OTTHUMP00000233475 antibody
OTTHUMP00000233476 antibody
OTTHUMP00000233900 antibody
p65 antibody
p65 NF kappaB antibody
p65 NFkB antibody
relA antibody
TF65_HUMAN antibody
Transcription factor p65 antibody
v rel avian reticuloendotheliosis viral oncogene homolog A (nuclear factor of kappa light polypeptide gene enhancer in B cells 3 (p65)) antibody
V rel avian reticuloendotheliosis viral oncogene homolog A antibody
v rel reticuloendotheliosis viral oncogene homolog A (avian) antibody
V rel reticuloendotheliosis viral oncogene homolog A, nuclear factor of kappa light polypeptide gene enhancer in B cells 3, p65 antibody
NF-κB p65
NF κB p65
NF-κB p65
折叠图片
-

☑ Knockout (KO)
Western blot analysis of NF-kB p65 on different lysates with Rabbit anti-NF-kB p65 antibody (HA750058) at 1/5,000 dilution.
Lane 1: Wild-type HeLa cell lysate
Lane 2: HeLa KO cell lysate
Lysates/proteins at 20 µg/Lane.
Predicted band size: 65 kDa
Observed band size: 65 kDa
Exposure time: 10 seconds; ECL: K1801;
4-20% SDS-PAGE gel.
Proteins were transferred to a PVDF membrane and blocked with 5% NFDM/TBST for 1 hour at room temperature. The primary antibody (HA750058) at 1/5,000 dilution was used in 5% NFDM/TBST at 4℃ overnight. Goat Anti-Rabbit IgG - HRP Secondary Antibody (HA1001) at 1/50,000 dilution was used for 1 hour at room temperature. -

Western blot analysis of NF-kB p65 on different lysates with Rabbit anti-NF-kB p65 antibody (HA750058) at 1/5,000 dilution.
Lane 1: A549 cell lysate
Lane 2: MCF7 cell lysate
Lane 3: HeLa cell lysate
Lane 4: RAW264.7 cell lysate
Lysates/proteins at 15 µg/Lane.
Predicted band size: 65 kDa
Observed band size: 65 kDa
Exposure time: 49 seconds; ECL: K1801;
4-20% SDS-PAGE gel.
Proteins were transferred to a PVDF membrane and blocked with 5% NFDM/TBST for 1 hour at room temperature. The primary antibody (HA750058) at 1/5,000 dilution was used in 5% NFDM/TBST at room temperature for 2 hours. Goat Anti-Rabbit IgG - HRP Secondary Antibody (HA1001) at 1:100,000 dilution was used for 1 hour at room temperature. -

☑ Knockdown (KD)
Western blot analysis of NF-kB p65 on different lysates with Rabbit anti-NF-kB p65 antibody (HA750058) at 1/5,000 dilution.
Lane 1: HAP1-parental cell lysate
Lane 2: HAP1-NF-kB p65 KD cell lysate
Lysates/proteins at 10 µg/Lane.
Predicted band size: 65 kDa
Observed band size: 65 kDa
Exposure time: 60 seconds; ECL: K1801;
4-20% SDS-PAGE gel.
Proteins were transferred to a PVDF membrane and blocked with 5% NFDM/TBST for 1 hour at room temperature. The primary antibody (HA750058) at 1/5,000 dilution was used in K1803 at 4℃ overnight. Goat Anti-Rabbit IgG - HRP Secondary Antibody (HA1001) at 1/50,000 dilution was used for 1 hour at room temperature. -

☑ Cell treatment (CT)
Immunocytochemistry analysis of HeLa cells treated with or without 50 ng/mL TNF-alpha for 20 minutes labeling NF-kB p65 with Rabbit anti-NF-kB p65 antibody (HA750058) at 1/400 dilution.
Cells were fixed in 4% paraformaldehyde for 10 minutes at 37 ℃, permeabilized with 0.05% Triton X-100 in PBS for 20 minutes, and then blocked with 2% negative goat serum for 30 minutes at room temperature. Cells were then incubated with Rabbit anti-NF-kB p65 antibody (HA750058) at 1/400 dilution in 2% negative goat serum overnight at 4 ℃. Goat Anti-Rabbit IgG H&L (iFluor™ 488, HA1121) was used as the secondary antibody at 1/1,000 dilution. Nuclear DNA was labelled in blue with DAPI.
Beta tubulin (M1305-2, red) was stained at 1/100 dilution overnight at +4℃. Goat Anti-Mouse IgG H&L (iFluor™ 594, HA1126) was used as the secondary antibody at 1/1,000 dilution. -

Immunohistochemical analysis of paraffin-embedded human lung squamous cell carcinoma tissue with Rabbit anti-NF-kB p65 antibody (HA750058) at 1/400 dilution.
The section was pre-treated using heat mediated antigen retrieval with Tris-EDTA buffer (pH 9.0) for 20 minutes. The tissues were blocked in 1% BSA for 20 minutes at room temperature, washed with ddH2O and PBS, and then probed with the primary antibody (HA750058) at 1/400 dilution for 1 hour at room temperature. The detection was performed using an HRP conjugated compact polymer system. DAB was used as the chromogen. Tissues were counterstained with hematoxylin and mounted with DPX. -

Immunohistochemical analysis of paraffin-embedded human lung cancer tissue with Rabbit anti-NF-kB p65 antibody (HA750058) at 1/200 dilution.
The section was pre-treated using heat mediated antigen retrieval with sodium citrate buffer (pH 6.0) (high pressure) for 2 minutes. The tissues were blocked in 1% BSA for 20 minutes at room temperature, washed with ddH2O and PBS, and then probed with the primary antibody (HA750058) at 1/200 dilution for 1 hour at room temperature. The detection was performed using an HRP conjugated compact polymer system. DAB was used as the chromogen. Tissues were counterstained with hematoxylin and mounted with DPX. -

Immunohistochemical analysis of paraffin-embedded human lung tissue with Rabbit anti-NF-kB p65 antibody (HA750058) at 1/200 dilution.
The section was pre-treated using heat mediated antigen retrieval with sodium citrate buffer (pH 6.0) (high pressure) for 2 minutes. The tissues were blocked in 1% BSA for 20 minutes at room temperature, washed with ddH2O and PBS, and then probed with the primary antibody (HA750058) at 1/200 dilution for 1 hour at room temperature. The detection was performed using an HRP conjugated compact polymer system. DAB was used as the chromogen. Tissues were counterstained with hematoxylin and mounted with DPX. -
Immunohistochemical analysis of paraffin-embedded human spleen tissue with Rabbit anti-NF-kB p65 antibody (HA750058) at 1/200 dilution.
The section was pre-treated using heat mediated antigen retrieval with sodium citrate buffer (pH 6.0) (high pressure) for 2 minutes. The tissues were blocked in 1% BSA for 20 minutes at room temperature, washed with ddH2O and PBS, and then probed with the primary antibody (HA750058) at 1/200 dilution for 1 hour at room temperature. The detection was performed using an HRP conjugated compact polymer system. DAB was used as the chromogen. Tissues were counterstained with hematoxylin and mounted with DPX. -

Immunohistochemical analysis of paraffin-embedded mouse spleen tissue with Rabbit anti-NF-kB p65 antibody (HA750058) at 1/200 dilution.
The section was pre-treated using heat mediated antigen retrieval with sodium citrate buffer (pH 6.0) (high pressure) for 2 minutes. The tissues were blocked in 1% BSA for 20 minutes at room temperature, washed with ddH2O and PBS, and then probed with the primary antibody (HA750058) at 1/200 dilution for 1 hour at room temperature. The detection was performed using an HRP conjugated compact polymer system. DAB was used as the chromogen. Tissues were counterstained with hematoxylin and mounted with DPX. -

Immunohistochemical analysis of paraffin-embedded rat spleen tissue with Rabbit anti-NF-kB p65 antibody (HA750058) at 1/200 dilution.
The section was pre-treated using heat mediated antigen retrieval with sodium citrate buffer (pH 6.0) (high pressure) for 2 minutes. The tissues were blocked in 1% BSA for 20 minutes at room temperature, washed with ddH2O and PBS, and then probed with the primary antibody (HA750058) at 1/200 dilution for 1 hour at room temperature. The detection was performed using an HRP conjugated compact polymer system. DAB was used as the chromogen. Tissues were counterstained with hematoxylin and mounted with DPX. -

NF-κB p65 was immunoprecipitated from 0.5 mg Hela whole cell lysates with HA750058 at 2 μg/mL. Western blot was performed from the immunoprecipitate using ET1603-12 at 1/500 dilution for 45 minutes at room temperature. Goat anti-Rabbit IgG-HRP Secondary Antibody (HA1001) was used at 1:300,000 dilution for 30 minutes at room temperature.
Lane 1: Hela whole cell lysates at 10 μg;
Lane 2: NF-κB p65 (ET1603-12) IP in Hela whole cell lysates;
Lane 3: Rabbit IgG instead of NF-κB p65 (ET1603-12) in Hela whole cell lysates.
Predicted band size: 60 kDa
Observed band size: 65 kDa
Exposure time: 10 seconds;
8% SDS-PAGE gel. -

Flow cytometric analysis of HeLa cells labeling NF-kB p65.
Cells were fixed and permeabilized. Then stained with the primary antibody (HA750058, red) at 1/2,000 dilution, compared with Rabbit IgG Isotype Control (green). After incubation of the primary antibody at +4℃ for an hour, the cells were stained with a iFluor™ 488 conjugate-Goat anti-Rabbit IgG Secondary antibody (HA1121) at 1/1,000 dilution for 30 minutes at +4℃. Unlabelled sample was used as a control (cells without incubation with primary antibody; black).
请注意: All products are "FOR RESEARCH USE ONLY AND ARE NOT INTENDED FOR DIAGNOSTIC OR THERAPEUTIC USE"
引文
-
Shengxian Decoction mitigate bleomycin-induced pulmonary fibrosis in mice via MerTK mediated macrophage efferocytosis
期刊: Journal Of Ethnopharmacology
DOI: 10.1016/j.jep.2026.121583
IF: 5.4
应用: WB
反应种属: Mouse
发表时间: 2026 Mar
-
The Single and Combined Effects of Decabromodiphenyl Ethane and Mixed Microplastics on Male Mice Reproductive Toxicity
期刊: Biology Of Reproduction
DOI: 10.1093/biolre/ioaf121
IF: 3.1
应用: WB
反应种属: Mouse
发表时间: 2025 May
-
Green tea epigallocatechin gallate attenuate metabolic dysfunction-associated steatotic liver disease by regulation of pyroptosis
期刊: Lipids in Health and Disease
DOI: 10.1186/s12944-025-02596-5
IF: 3.9
应用: WB
反应种属: Zebrafish
发表时间: 2025 May
同靶点 & 同通路的产品
NF-kB p65 Recombinant Rabbit Monoclonal Antibody [PSH0-27] - BSA and Azide free
Application: WB,IHC-P,IF-Cell,FC
Reactivity: Human,Mouse,Rat,Green monkey
Conjugate: unconjugated
NF-kB p65 Recombinant Rabbit Monoclonal Antibody [SZ10-04]
Application: WB,IF-Cell,IF-Tissue,IHC-P,IP,FC
Reactivity: Human,Mouse,Rat,Zebrafish
Conjugate: unconjugated
Phospho-NF-kB p65 (S529) Recombinant Rabbit Monoclonal Antibody [SP07-00]
Application: WB,IHC-P,FC,IP
Reactivity: Human
Conjugate: unconjugated
NF-kB p65 Recombinant Rabbit Monoclonal Antibody [PSH0-27]
Application: WB,IHC-P,IF-Cell,FC
Reactivity: Human,Mouse,Rat,Green monkey
Conjugate: unconjugated
Phospho-NF-kB p65 (S529) Recombinant Rabbit Monoclonal Antibody [SP07-00] - BSA and Azide free
Application: WB,IHC-P,FC,IP
Reactivity: Human
Conjugate: unconjugated
NF-kB p65 Rabbit Polyclonal Antibody
Application: WB,IHC-P,FC
Reactivity: Human,Mouse,Rat,Zebrafish
Conjugate: unconjugated
NF-kB p65 Rabbit Polyclonal Antibody
Application: WB,IHC-P,IF-Cell,FC,IP
Reactivity: Human,Mouse,Rat
Conjugate: unconjugated
Phospho-NF-kB p65 (S536) Recombinant Rabbit Monoclonal Antibody [PSH10-58] - BSA and Azide free
Application: WB,IF-Cell
Reactivity: Human,Mouse,Rat
Conjugate: unconjugated
Phospho-NF-kB p65 (S536) Recombinant Rabbit Monoclonal Antibody [PSH10-58]
Application: WB,IF-Cell
Reactivity: Human,Mouse,Rat
Conjugate: unconjugated











 浙公网安备 33019202000643号
浙公网安备 33019202000643号